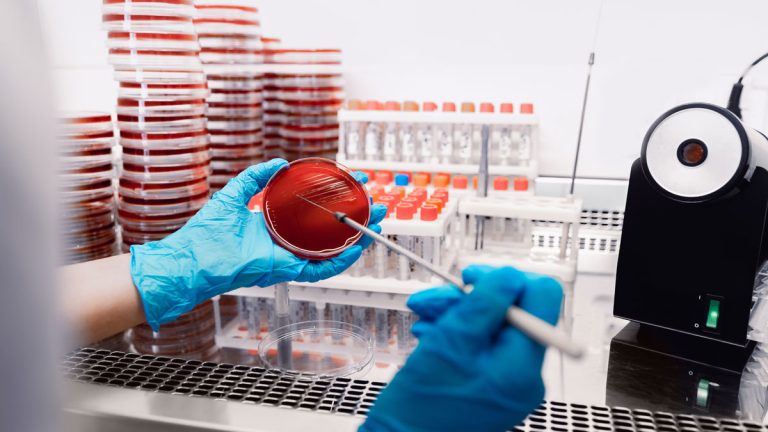
Kültür Antibiyogram Testi

Kültür Antibiyogram Testi
Kültür antibiyogram testi, enfeksiyona neden olan mikroorganizmayı belirlemek ve bu mikroorganizmaya karşı etkili antibiyotiği saptamak için yapılan laboratuvar testidir. Bu test, enfeksiyonların doğru tedavi edilmesini sağlayarak yanlış veya gereksiz antibiyotik kullanımını önler. Böylece hem tedavi süresi kısalır hem de antibiyotik direncinin gelişmesi engellenir.
Kültür antibiyogram testi iki aşamadan oluşur. İlk aşamada “kültür testi” ile hastadan alınan örnekte enfeksiyona neden olan mikroorganizma laboratuvar ortamında üretilir. İkinci aşamada ise “antibiyogram testi” yapılarak bu mikroorganizmanın farklı antibiyotiklere karşı duyarlılık ve direnç profili belirlenir. Elde edilen veriler, hekimin hangi antibiyotiğin en etkili olduğunu seçmesine yardımcı olur ve hastaya özel tedavi planı oluşturulmasını sağlar.
Kültür ve Antibiyogram Testi Arasındaki Fark Nedir?
Kültür ve antibiyogram testi, enfeksiyon tanısında birlikte kullanılan ancak farklı amaçlara hizmet eden iki aşamalı testtir. Kültür testi, enfeksiyona neden olan mikroorganizmayı üreterek türünü belirlemeyi sağlar; antibiyogram testi ise bu mikroorganizmanın hangi antibiyotiklere duyarlı veya dirençli olduğunu gösterir.
Kültür testi sayesinde bakterinin veya mantarın kimliği saptanır. Bu bilgi, antibiyogram aşamasında hangi antibiyotiklerin test edileceğini belirler. Antibiyogram ise kültürde üreyen mikroorganizmaya farklı antibiyotiklerin uygulanmasıyla gerçekleştirilir ve sonuç “duyarlı, dirençli veya orta duyarlı” şeklinde raporlanır. Böylece kültür testi “etkeni bulma”, antibiyogram testi ise “doğru ilacı seçme” amacını taşır; birlikte uygulandığında enfeksiyon tedavisinde en yüksek doğruluk sağlanır.
Kültür Antibiyogram Testi Ne İşe Yarar?
Kültür antibiyogram testi, enfeksiyona neden olan mikroorganizmayı tanımlayarak hastaya en etkili antibiyotiğin seçilmesini sağlar. Bu test, özellikle tekrarlayan veya tedaviye yanıt vermeyen enfeksiyonlarda, doğru ilaç kullanımını belirlemek açısından kritik öneme sahiptir. Doğru antibiyotik seçimi sayesinde hem tedavi süresi kısalır hem de gereksiz antibiyotik kullanımı önlenir.
Test, bakteriyel veya mantar kaynaklı enfeksiyonlarda mikroorganizmanın laboratuvar ortamında üretilip hangi antibiyotiklere duyarlı olduğunu gösterir. Bu sayede hekim, enfeksiyonu hedefe yönelik biçimde tedavi edebilir. Ayrıca toplumda giderek artan antibiyotik direnci sorununa karşı akılcı antibiyotik kullanımını destekler. Kültür antibiyogram testi, tıbbın kişiye özel tedavi yaklaşımının en önemli araçlarından biridir ve enfeksiyon kontrolünde bilimsel rehber niteliği taşır.
Kültür Antibiyogram Testi Nasıl Yapılır?
Kültür antibiyogram testi, enfeksiyonun bulunduğu bölgeden alınan örneğin laboratuvar ortamında incelenmesiyle yapılır. Bu örnek; idrar, kan, balgam, vajinal akıntı, boğaz sürüntüsü veya yara kültürü gibi materyaller olabilir. Testin amacı, enfeksiyona neden olan mikroorganizmayı üretmek ve ardından hangi antibiyotiğe duyarlı olduğunu belirlemektir.
İlk aşamada, alınan örnek uygun besiyerine ekilerek mikroorganizmanın üremesi sağlanır. Üreyen mikroorganizma tanımlandıktan sonra antibiyogram aşamasına geçilir. Bu aşamada farklı antibiyotikler test edilerek mikroorganizmanın duyarlılık profili belirlenir. Sonuç, laboratuvar raporunda “duyarlı”, “dirençli” veya “orta duyarlı” olarak bildirilir. Tüm bu süreç steril koşullarda, ileri mikrobiyolojik analizlerle gerçekleştirilir ve sonuçlar uzman hekim tarafından değerlendirilerek tedaviye yön verir.
Hangi Durumlarda Kültür Antibiyogram Testi Yapılır?
Kültür antibiyogram testi, enfeksiyon bulguları olan ve antibiyotik tedavisine rağmen iyileşmeyen hastalarda yapılır. Özellikle ateş, ağrı, iltihap, kötü kokulu akıntı veya tekrarlayan enfeksiyonlar bu testin gerekli olduğunu gösterir. Amaç, enfeksiyonun nedenini saptayarak en etkili antibiyotik tedavisini belirlemektir.
Bu test en sık idrar yolu enfeksiyonları, boğaz enfeksiyonları, cilt ve yara enfeksiyonları, solunum yolu enfeksiyonları, genital enfeksiyonlar ve kan dolaşımı enfeksiyonlarında kullanılır. Ayrıca bağışıklık sistemi zayıf bireylerde, hastane enfeksiyonları veya uzun süre antibiyotik kullanımı sonrası da tercih edilir. Kültür antibiyogram testi, doğru tedavi seçimini sağlayarak antibiyotik direncinin gelişmesini önler ve toplum sağlığının korunmasına katkıda bulunur.
Kültür Antibiyogram Testi Hangi Örneklerden Yapılır?
Kültür antibiyogram testi, enfeksiyonun bulunduğu bölgeye göre farklı vücut örneklerinden yapılabilir. En sık kullanılan örnekler arasında idrar, kan, balgam, boğaz sürüntüsü, vajinal akıntı ve yara kültürü yer alır. Her örnek türü, enfeksiyonun kaynağına ve mikrobiyolojik yapısına göre özel koşullarda incelenir.
İdrar kültürü, idrar yolu enfeksiyonlarını; boğaz kültürü, farenjit veya tonsilit gibi üst solunum yolu enfeksiyonlarını; vajinal kültür, kadınlarda genital enfeksiyonları belirlemeye yarar. Balgam kültürü, akciğer enfeksiyonlarının tanısında; yara kültürü ise cilt ve yumuşak doku enfeksiyonlarının değerlendirilmesinde kullanılır. Her örnek, steril koşullarda alınmalı ve kısa sürede laboratuvara ulaştırılmalıdır. Bu sayede kültür antibiyogram testi doğru ve güvenilir sonuç verir.
Kültür Antibiyogram Testi Sonucu Ne Zaman Çıkar?
Kültür antibiyogram testi sonucu, alınan örnekteki mikroorganizmanın üreme hızına bağlı olarak genellikle 24 ila 72 saat içinde çıkar. Ancak bazı durumlarda, özellikle yavaş üreyen bakteriler veya mantarlarda, sonuç süresi birkaç günü bulabilir. Bu süre, laboratuvarın teknik donanımına ve örnek türüne göre değişiklik gösterebilir.
İlk olarak kültür aşamasında mikroorganizmanın üremesi beklenir. Üreme tamamlandıktan sonra antibiyogram aşamasına geçilerek antibiyotik duyarlılık testi yapılır. Laboratuvar raporunda, mikroorganizmanın her antibiyotiğe karşı durumu “duyarlı”, “orta duyarlı” veya “dirençli” şeklinde belirtilir. Kültür antibiyogram testi sonuçları, hekim tarafından değerlendirilerek hastaya en uygun tedavi planı oluşturulur.
Kültür Antibiyogram Testi Sonucu Nasıl Yorumlanır?
Kültür antibiyogram testi sonucu, mikroorganizmanın farklı antibiyotiklere karşı duyarlılığını gösteren bilimsel bir rapor şeklinde değerlendirilir. Raporda yer alan “duyarlı (S)”, “orta duyarlı (I)” ve “dirençli (R)” ifadeleri, mikroorganizmanın ilgili antibiyotiğe nasıl tepki verdiğini belirtir. Bu sonuç, hekim için hangi antibiyotiğin tedavide etkili olacağını belirlemede yol göstericidir.
Eğer sonuçta mikroorganizma belirli bir antibiyotiğe duyarlı olarak raporlanmışsa, bu ilaç tedavide yüksek başarı sağlar. “Dirençli” sonucu ise antibiyotiğin etkili olmayacağını gösterir ve kullanılmamalıdır. “Orta duyarlı” ifadesi, ilacın bazı dozlarda etkili olabileceğini ancak dikkatli değerlendirme gerektiğini ifade eder. Kültür antibiyogram testi, tedavinin kişiye özel planlanmasını sağlayarak gereksiz antibiyotik kullanımını önleyen en güvenilir laboratuvar testlerinden biridir.
Kültür Antibiyogram Testi Öncesi Dikkat Edilmesi Gerekenler
Kültür antibiyogram testi öncesi, testin doğru sonuç vermesi için bazı önemli noktalara dikkat edilmelidir. En önemli kural, antibiyotik kullanılmadan önce testin yapılmasıdır. Çünkü antibiyotik kullanımı, mikroorganizmaların üremesini engelleyerek kültür sonucunun yanlış çıkmasına neden olabilir.
Testten önce örnek alınacak bölge temiz tutulmalı, idrar veya vajinal kültür yapılacaksa numune sabah ilk saatlerde alınmalıdır. Kan veya balgam örnekleri için ise hastanın aç olması gerekebilir. Laboratuvar görevlisinin önerdiği steril toplama koşullarına uyulması testin güvenilirliğini artırır. Kültür antibiyogram testi, doğru şekilde uygulandığında enfeksiyonun nedenini en yüksek doğrulukla belirler ve tedavi sürecine rehberlik eder.
Kültür Antibiyogram Testi Sonuçları Ne Anlama Gelir?
Kültür antibiyogram testi sonuçları, enfeksiyona neden olan mikroorganizmanın türünü ve bu mikroorganizmanın farklı antibiyotiklere karşı duyarlılık durumunu gösterir. Laboratuvar raporunda yer alan “duyarlı (S)”, “orta duyarlı (I)” ve “dirençli (R)” ifadeleri, hekimin hangi antibiyotiği seçmesi gerektiğini belirlemesinde en önemli kriterlerdir.
Duyarlı (S) sonucu, antibiyotiğin mikroorganizma üzerinde etkili olduğunu gösterir ve tedavide güvenle kullanılabilir. Dirençli (R) sonucu ise antibiyotiğin işe yaramayacağını, bu nedenle alternatif ilaçlara yönelmek gerektiğini belirtir. Orta duyarlı (I) ifadesi, antibiyotiğin belirli dozlarda kısmen etkili olabileceğini anlatır. Bu veriler, kişiye özel antibiyotik tedavisinin planlanmasını sağlar ve antibiyotik direncinin yayılmasını önlemede büyük rol oynar.
Kültür Antibiyogram Testi Fiyatı
Kültür antibiyogram testi fiyatı, alınan örnek türüne, testin kapsamına ve laboratuvarın teknik altyapısına göre laboratuvarlarda ortalama 2200 TL – 3800 TL arasındadır. Genellikle örnek türü (idrar, kan, balgam, vajinal akıntı vb.) ve analiz sürecinin detayına bağlı olarak fiyat belirlenir. Ayrıca laboratuvarın donanımı, kullanılan cihazlar ve raporlama hızı da fiyat üzerinde etkili olabilir.
Kültür antibiyogram testinde maliyetten çok doğru tanı ve güvenilir sonuç ön planda olmalıdır. Çünkü yanlış sonuç, hem tedavinin uzamasına hem de antibiyotik direncinin gelişmesine neden olabilir. Mavi Laboratuvarlar Grubu, ileri mikrobiyolojik analiz teknolojileri ve deneyimli uzman doktor kadrosuyla kültür antibiyogram testini uluslararası standartlara uygun biçimde gerçekleştirir ve sonuçları kısa sürede güvenilir şekilde sunar.
Kültür Antibiyogram Testi Nerede Yapılır?
Kültür antibiyogram testi, mikrobiyoloji alanında uzmanlık gerektiren, donanımlı klinik laboratuvarlarda yapılmalıdır. Testin doğru sonuç vermesi için örneklerin steril koşullarda alınması, uygun besiyerlerinde incelenmesi ve deneyimli laboratuvar uzmanları tarafından değerlendirilmesi gerekir. Bu nedenle test, hastaneler, özel laboratuvarlar ve yetkili tıbbi tanı merkezlerinde uygulanmalıdır.
Mavi Laboratuvarlar Grubu, İstanbul’daki Çapa, Ataköy, Beykent ve Kozyatağı şubelerinde kültür antibiyogram testi hizmeti sunar. Her şubede, modern laboratuvar cihazlarıyla donatılmış test altyapısı ve enfeksiyon hastalıkları konusunda deneyimli laboratuvar doktorları görev yapar. Test sonuçları titizlikle değerlendirilir ve kısa sürede güvenilir biçimde raporlanır. Böylece hastalar, enfeksiyonun nedenini ve en etkili antibiyotik tedavisini aynı gün içinde öğrenebilir.
Sık Sorulan Sorular (SSS)
Kültür antibiyogram testi kaç günde çıkar?
Kültür antibiyogram testi sonucu genellikle 24 ila 72 saat içinde çıkar. Ancak mikroorganizmanın türüne ve laboratuvarın yoğunluğuna bağlı olarak bu süre değişebilir. Bazı yavaş üreyen bakterilerde sonuç birkaç günü bulabilir.
Antibiyotik kullanırken kültür antibiyogram testi yapılır mı?
Antibiyotik kullanımı, mikroorganizmaların üremesini engellediği için testin doğruluğunu düşürür. Bu nedenle kültür antibiyogram testi, antibiyotik tedavisine başlanmadan önce yapılmalıdır.
Kültür antibiyogram testi pozitif çıkarsa ne olur?
Pozitif sonuç, örnekte enfeksiyon etkeni bir mikroorganizmanın ürediğini gösterir. Bu durumda antibiyogram aşaması uygulanır ve enfeksiyona en etkili antibiyotik belirlenerek tedavi planlanır.
Kültür antibiyogram testi negatif çıkarsa ne anlama gelir?
Negatif sonuç, örnekte mikroorganizma üremediği anlamına gelir. Bu durumda enfeksiyonun nedeni başka bir etken olabilir veya örnek yanlış zamanda alınmış olabilir.
Kültür antibiyogram testi neden önemlidir?
Bu test, doğru antibiyotiğin seçilmesini sağlayarak tedavi başarısını artırır, gereksiz antibiyotik kullanımını önler ve toplumda antibiyotik direncinin gelişmesini engeller.